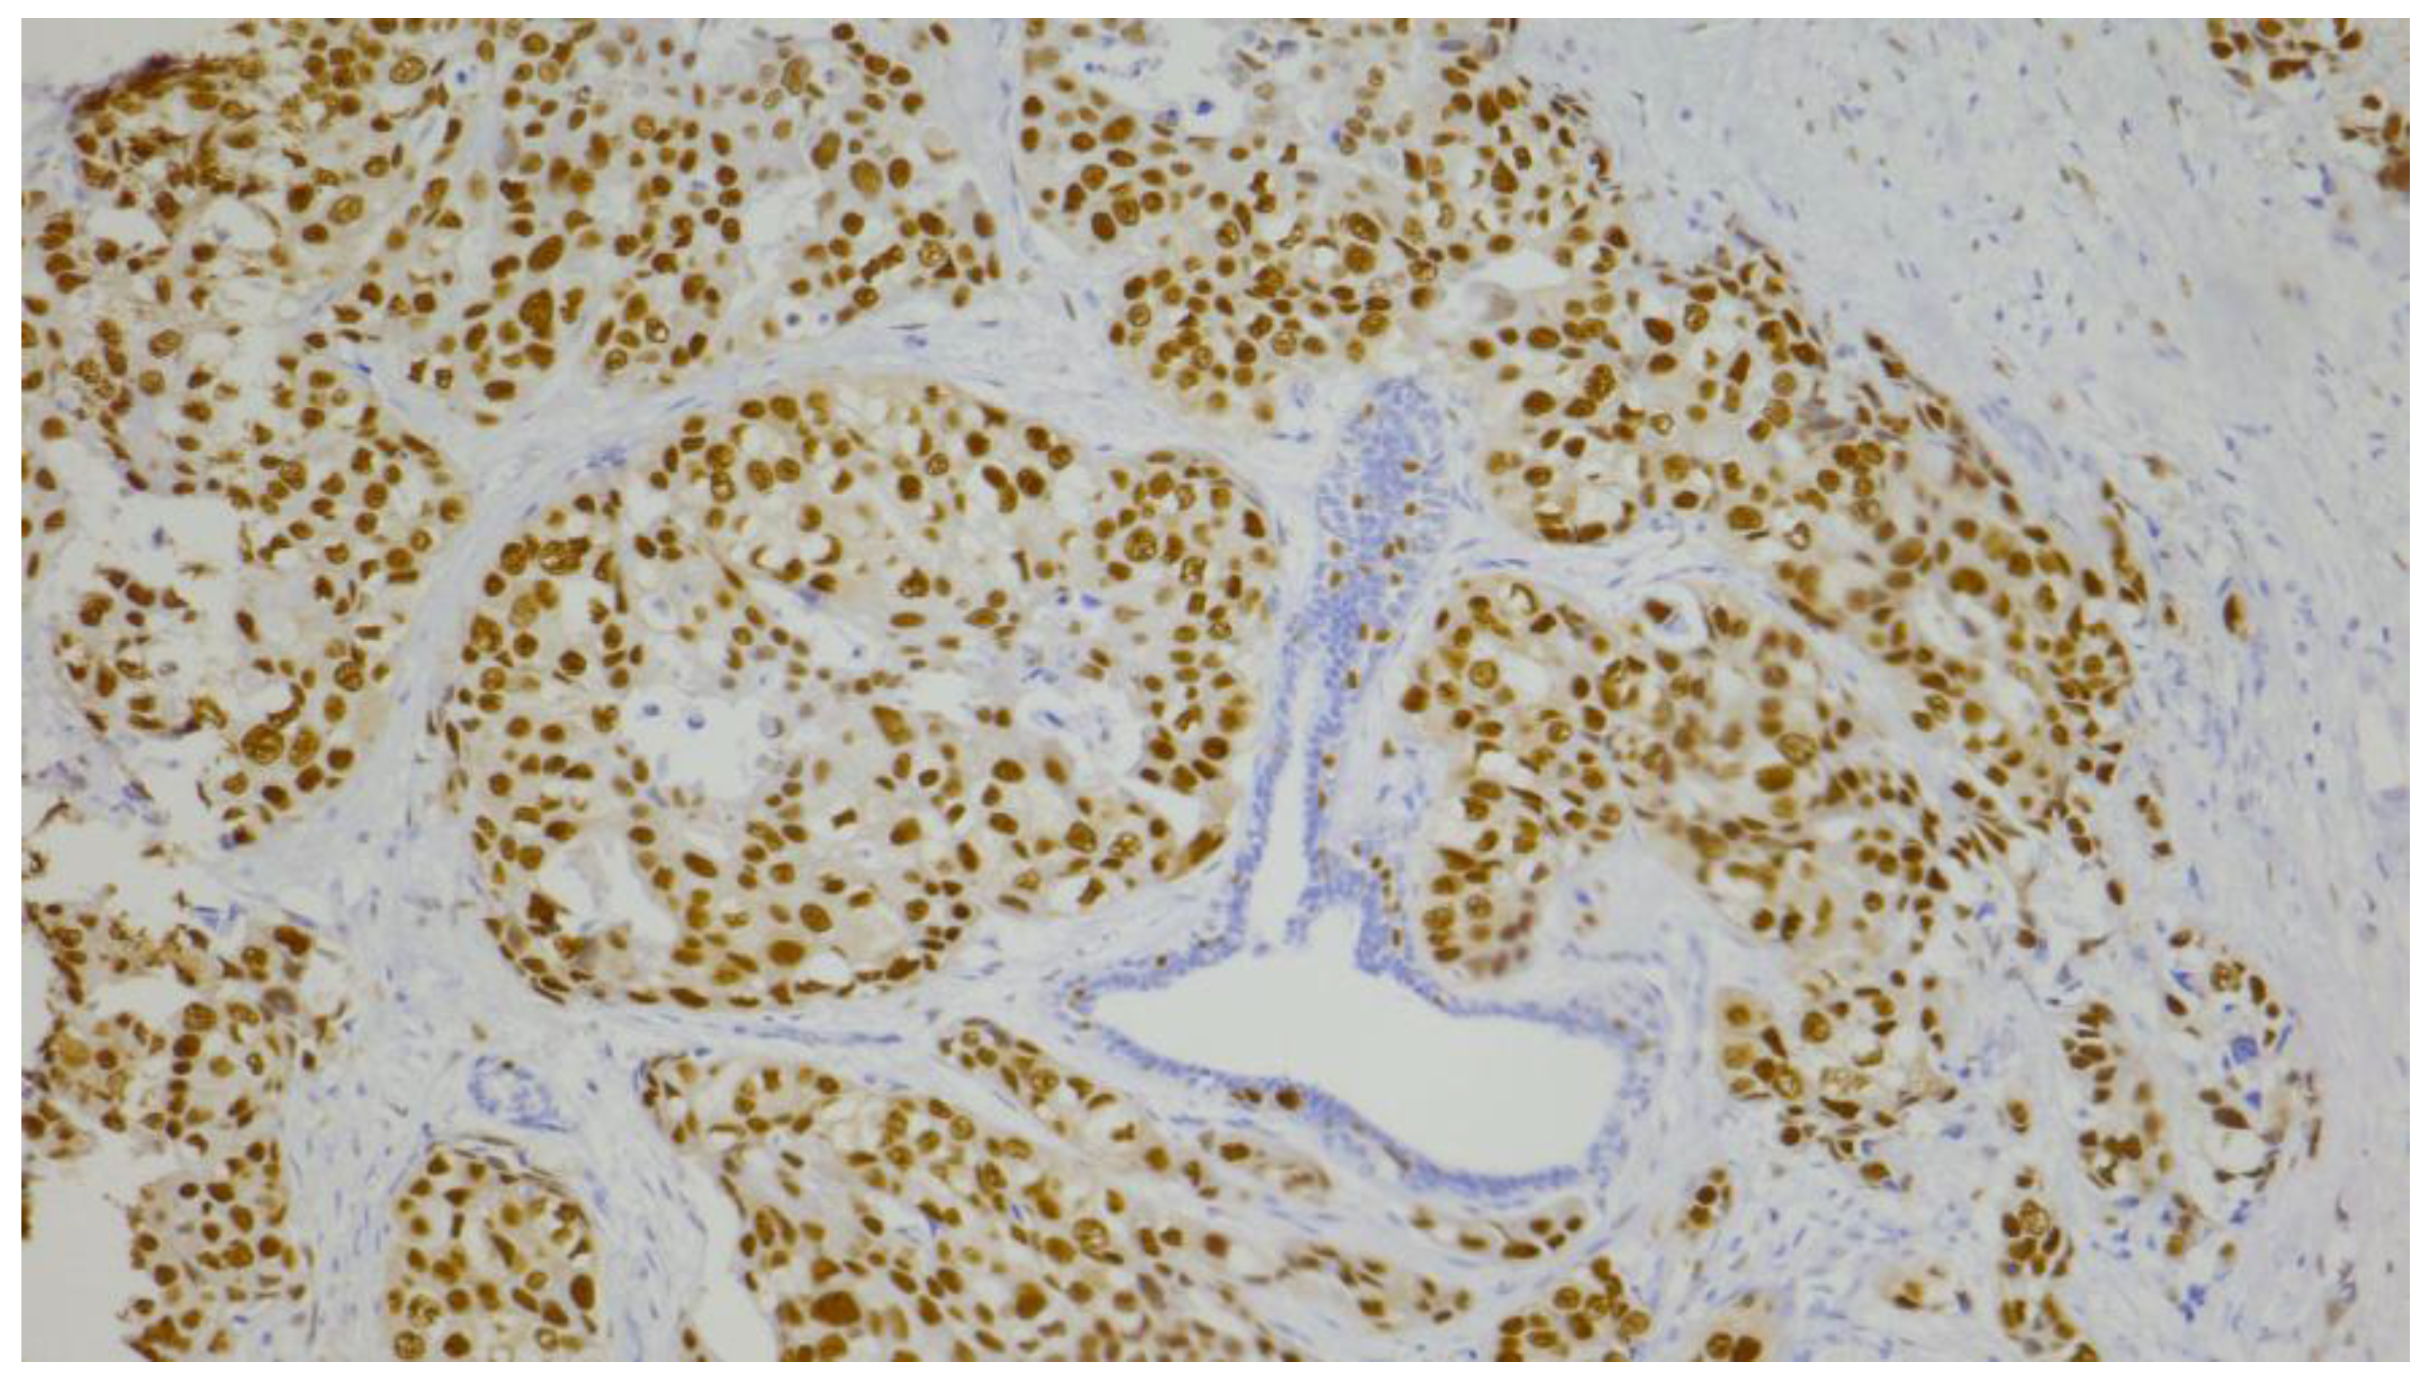

The Diagnostics of Disease Relapse Within Five-Year Follow-Up and the Role of Androgen Receptor Expression in Patients with Early Triple-Negative Breast Cancer
Abstract
1. Introduction
2. Materials and Methods
2.1. Patients
2.2. Histopathological Characteristics of the Tumor
2.3. Immunohistochemical Analyses
2.3.1. Automated Immunohistochemical Method
2.3.2. Manual Immunohistochemical Method
2.4. Evaluation of Immunohistochemical Staining
2.5. Statistical Analysis
3. Results
3.1. Patients, Disease, and Therapy Characteristics of the TNBC Cohort
3.2. Correlation of Clinicopathological Features, Treatment Characteristics, and Androgen Receptor Status
3.3. Univariate Analyses of Prognostic Factors for 5-Year Disease-Free Survival and Overall Survival
3.4. Multivariate Cox Regression Analysis of Prognostic Factors for 5-Year Disease-Free Survival and Overall Survival
4. Discussion
Author Contributions
Funding
Institutional Review Board Statement
Informed Consent Statement
Data Availability Statement
Acknowledgments
Conflicts of Interest
References
- Gerratana, L.; Basile, D.; Buono, G.; De Placido, S.; Giuliano, M.; Minichillo, S.; Coinu, A.; Martorana, F.; De Santo, I.; Del Mastro, L.; et al. Androgen receptor in triple negative breast cancer: A potential target for the targetless subtype. Cancer Treat. Rev. 2018, 68, 102–110. [Google Scholar] [CrossRef] [PubMed]
- Anestis, A.; Karamouzis, M.V.; Dalagiorgou, G.; Papavassiliou, A.G. Is androgen receptor targeting an emerging treatment strategy for triple negative breast cancer? Cancer Treat. Rev. 2015, 41, 547–553. [Google Scholar] [CrossRef] [PubMed]
- Lehmann, B.D.; Jovanović, B.; Chen, X.; Estrada, M.V.; Johnson, K.N.; Shyr, Y.; Moses, H.L.; Sanders, M.E.; Pietenpol, J.A. Refinement of Triple-Negative Breast Cancer Molecular Subtypes: Implications for Neoadjuvant Chemotherapy Selection. PLoS ONE 2016, 11, e0157368. [Google Scholar] [CrossRef] [PubMed]
- Lee, M.; Yoo, T.-K.; Chae, B.J.; Lee, A.; Cha, Y.J.; Lee, J.; Ahn, S.G.; Kang, J. Luminal androgen receptor subtype and tumor-infiltrating lymphocytes groups based on triple-negative breast cancer molecular subclassification. Sci. Rep. 2024, 14, 11278. [Google Scholar] [CrossRef]
- Collins, L.C.; Cole, K.S.; Marotti, J.D.; Hu, R.; Schnitt, S.J.; Tamimi, R.M. Androgen receptor expression in breast cancer in relation to molecular phenotype: Results from the Nurses’ Health Study. Mod. Pathol. 2011, 24, 924–931. [Google Scholar] [CrossRef]
- Wang, Y.; He, X.; Yu, Q.; Eng, C. Androgen receptor-induced tumor suppressor, KLLN, inhibits breast cancer growth and transcriptionally activates p53/p73-mediated apoptosis in breast carcinomas. Hum. Mol. Genet. 2013, 22, 2263–2272. [Google Scholar] [CrossRef]
- Christenson, J.L.; Butterfield, K.T.; Spoelstra, N.S.; Norris, J.D.; Josan, J.S.; Pollock, J.A.; McDonnell, D.P.; Katzenellenbogen, B.S.; Katzenellenbogen, J.A.; Richer, J.K. MMTV-PyMT and Derived Met-1 Mouse Mammary Tumor Cells as Models for Studying the Role of the Androgen Receptor in Triple-Negative Breast Cancer Progression. Horm. Cancer 2017, 8, 69–77. [Google Scholar] [CrossRef]
- Li, X.; Zou, L. BRCAness, DNA gaps, and gain and loss of PARP inhibitor–induced synthetic lethality. J. Clin. Investig. 2024, 134, e181062. [Google Scholar] [CrossRef]
- Sharifi, M.N.; O’Regan, R.M.; Wisinski, K.B. Is the Androgen Receptor a Viable Target in Triple Negative Breast Cancer in 5 Years? Clin. Breast Cancer 2023, 23, 813–824. [Google Scholar] [CrossRef]
- Khadela, A.; Chavda, V.P.; Soni, S.; Megha, K.; Pandya, A.J.; Vora, L. Anti Androgenic Therapies Targeting the Luminal Androgen Receptor of a Typical Triple-Negative Breast Cancer. Cancers 2023, 15, 233. [Google Scholar] [CrossRef]
- NCCN Guidelines. NCCN Clinical Practice Guidelines in Oncology (NCCN Guidelines®). Breast Cancer. Version 1.2025. Available online: https://www.nccn.org/guidelines/guidelines-detail?category=1&id=1419 (accessed on 22 February 2025).
- Wang, C.; Pan, B.; Zhu, H.; Zhou, Y.; Mao, F.; Lin, Y.; Xu, Q.; Sun, Q. Prognostic value of androgen receptor in triple negative breast cancer: A meta-analysis. Oncotarget 2016, 7, 46482–46491. [Google Scholar] [CrossRef] [PubMed]
- Kucukzeybek, B.B.; Bayoglu, I.V.; Kucukzeybek, Y.; Yıldız, Y.; Oflazoglu, U.; Atahan, M.K.; Taskaynatan, H.; Alacacioglu, A.; Yigit, S.; Tarhan, M.O. Prognostic significance of androgen receptor expression in HER2-positive and triple-negative breast cancer. Pol. J. Pathol. 2018, 69, 157–168. [Google Scholar] [CrossRef] [PubMed]
- Guiu, S.; Mollevi, C.; Charon-Barra, C.; Boissière, F.; Crapez, E.; Chartron, E.; Lamy, P.J.; Gutowski, M.; Bourgier, C.; Romieu, G.; et al. Prognostic value of androgen receptor and FOXA1 co-expression in non-metastatic triple negative breast cancer and correlation with other biomarkers. Br. J. Cancer 2018, 119, 76–79. [Google Scholar] [CrossRef] [PubMed]
- Hu, X.Q.; Chen, W.L.; Ma, H.G.; Jiang, K. Androgen receptor expression identifies patient with favorable outcome in operable triple negative breast cancer. Oncotarget 2017, 8, 56364–56374. [Google Scholar] [CrossRef]
- Asano, Y.; Kashiwagi, S.; Goto, W.; Tanaka, S.; Morisaki, T.; Takashima, T.; Noda, S.; Onoda, N.; Ohsawa, M.; Hirakawa, K.; et al. Expression and Clinical Significance of Androgen Receptor in Triple-Negative Breast Cancer. Cancers 2017, 9, 4. [Google Scholar] [CrossRef]
- Lyalkin, S.A.; Verevkina, N.O.; Alekseyenko, O.O.; Syvak, L.A. Prognostic role of androgen receptor expression in patients with metastatic triple negative breast cancer. Exp. Oncol. 2020, 42, 140–143. [Google Scholar] [CrossRef]
- Sang, M.; Meng, L.; Ma, C.; Liu, S.; Sang, M.; Chang, S.; Liu, F.; Lian, Y.; Geng, C. Effect of AR antagonist combined with PARP1 inhibitor on sporadic triple-negative breast cancer bearing AR expression and methylation-mediated BRCA1 dysfunction. Biomed. Pharmacother. 2019, 111, 169–177. [Google Scholar] [CrossRef]
- Jiang, H.S.; Kuang, X.Y.; Sun, W.L.; Xu, Y.; Zheng, Y.Z.; Liu, Y.R.; Lang, G.T.; Qiao, F.; Hu, X.; Shao, Z.M. Androgen receptor expression predicts different clinical outcomes for breast cancer patients stratified by hormone receptor status. Oncotarget 2016, 7, 41285–41293. [Google Scholar] [CrossRef]
- Zaborowski, M.; Pearson, A.; Sioson, L.; Gill, A.J.; Ahadi, M.S. Androgen receptor immunoexpression in triple-negative breast cancers: Is it a prognostic factor? Pathology 2019, 51, 327–329. [Google Scholar] [CrossRef]
- Nimeus, E.; Folkesson, E.; Nodin, B.; Hartman, L.; Klintman, M. Androgen receptor in stage I-II primary breast cancer–prognostic value and distribution in subgroups. Anticancer. Res. 2017, 37, 6845–6853. [Google Scholar]
- Liu, Y.X.; Zhang, K.J.; Tang, L.L. Clinical significance of androgen receptor expression in triple negative breast cancer—An immunohistochemistry study. Oncol. Lett. 2018, 15, 10008–10016. [Google Scholar] [CrossRef] [PubMed]
- Jongen, L.; Floris, G.; Wildiers, H.; Claessens, F.; Richard, F.; Laenen, A.; Desmedt, C.; Ardui, J.; Punie, K.; Smeets, A.; et al. Tumor characteristics and outcome by androgen receptor expression in triple-negative breast cancer patients treated with neo-adjuvant chemotherapy. Breast Cancer Res. Treat. 2019, 176, 699–708. [Google Scholar] [CrossRef] [PubMed]
- Dieci, M.V.; Tsvetkova, V.; Griguolo, G.; Miglietta, F.; Mantiero, M.; Tasca, G.; Cumerlato, E.; Giorgi, C.A.; Giarratano, T.; Faggioni, G.; et al. Androgen receptor expression and association with distant disease-free survival in triple negative breast cancer: Analysis of 263 patients treated with standard therapy for stage I-III disease. Front. Oncol. 2019, 9, 452. [Google Scholar] [CrossRef] [PubMed]
- Sridhar, N.; Glisch, C.; Jawa, Z.; Chaudhary, L.N.; Kamaraju, S.; Burfeind, J.; Charlson, J.; Chitambar, C.R.; Jorns, J.M.; Cheng, Y.C. Androgen receptor expression in patients with triple negative breast cancer treated with neoadjuvant chemotherapy: A single institution study. J. Cancer 2022, 13, 2472–2476. [Google Scholar] [CrossRef]
- Xu, M.; Yuan, Y.; Yan, P.; Jiang, J.; Ma, P.; Niu, X.; Ma, S.; Cai, H.; Yang, K. Prognostic Significance of Androgen Receptor Expression in Triple Negative Breast Cancer: A Systematic Review and Meta-Analysis. Clin. Breast Cancer 2020, 20, e385–e396. [Google Scholar] [CrossRef]
- Dubrava, A.L.; Kyaw, P.S.P.; Newman, J.; Pringle, J.; Westhuyzen, J.; La Hera Fuentes, G.; Shakespeare, T.P.; Sakalkale, R.; Aherne, N.J. Androgen Receptor Status in Triple Negative Breast Cancer: Does It Correlate with Clinicopathological Characteristics? Breast Cancer Targets Ther. 2023, 15, 359–371. [Google Scholar] [CrossRef]
- Vera-Badillo, F.E.; Templeton, A.J.; de Gouveia, P.; Diaz-Padilla, I.; Bedard, P.L.; Al-Mubarak, M.; Seruga, B.; Tannock, I.F.; Ocana, A.; Amir, E. Androgen receptor expression and outcomes in early breast cancer: A systematic review and meta-analysis. J. Natl. Cancer Inst. 2014, 106, djt319. [Google Scholar] [CrossRef]
- Kataja, V.; Castiglione, M.; ESMO Guidelines Working Group. Primary breast cancer: ESMO clinical recommendations for diagnosis, treatment and follow-up. Ann. Oncol. 2009, 20, 10–14. [Google Scholar] [CrossRef]
- Aebi, S.; Davidson, T.; Gruber, G.; Castiglione, M.; ESMO Guidelines Committee. Primary breast cancer: ESMO Clinical Practice Guidelines for diagnosis, treatment and follow-up. Ann. Oncol. 2010, 21, 9–14. [Google Scholar] [CrossRef]
- Aebi, S.; Davidson, T.; Gruber, G.; Cardoso, F.; ESMO Guidelines Committee. Primary breast cancer: ESMO Clinical Practice Guidelines for diagnosis, treatment and follow-up. Ann. Oncol. 2011, 22, 12–24. [Google Scholar] [CrossRef]
- Senkus, E.; Kyriakides, S.; Ohno, S.; Penault-Llorca, F.; Poortmans, P.; Rutgers, E.; Zackrisson, S.; Cardoso, F.; ESMO Guidelines Committee. Primary breast cancer: ESMO Clinical Practice Guidelines for diagnosis, treatment and follow-up. Ann. Oncol. 2015, 26, v8–v30. [Google Scholar] [CrossRef] [PubMed]
- Lakhani, S.R.; Ellis, I.O.; Schnitt, S.J.; Tan, P.H.; van de Vijver, M.J. WHO Classification of Tumours of the Breast, 4th ed.; IARC Press: Lyon, France, 2012. [Google Scholar]
- Elston, C.W.; Ellis, I.O. Pathological prognostic factors in breast cancer. I. The value of histological grade in breast cancer: Experience from a large study with long-term follow-up. Histopathology 1991, 19, 403–410. [Google Scholar] [CrossRef] [PubMed]
- Sobin, L.H.; Gospodarowicz, M.K.; Wittekind, C. TNM Classification of Malignant Tumours, 7th ed.; International Union Against Cancer Wiley–Blackwell: Geneva, Switzerland, 2009. [Google Scholar]
- Allred, D.C.; Harvey, J.M.; Berardo, M.; Clark, G.M. Prognostic and predictive factors in breast cancer by immunohistochemical analysis. Mod. Pathol. 1998, 11, 155–168. [Google Scholar] [PubMed]
- Dias, K.; Dvorkin-Gheva, A.; Hallett, R.M.; Wu, Y.; Hassell, J.; Pond, G.R.; Levine, M.; Whelan, T.; Bane, A.L. Claudin-Low Breast Cancer; Clinical & Pathological Characteristics. PLoS ONE 2017, 12, e0168669. [Google Scholar] [CrossRef]
- Hammond, M.E.H.; Hayes, D.F.; Dowsett, M.; Allred, D.C.; Hagerty, K.L.; Badve, S.; Fitzgibbons, P.L.; Francis, G.; Goldstein, N.S.; Hayes, M.; et al. American Society of Clinical Oncology/College of American Pathologists guideline recommendations for immunohistochemical testing of estrogen and progesterone receptors in breast cancer (unabridged version). Arch. Pathol. Lab. Med. 2010, 134, e48–e72. [Google Scholar] [CrossRef]
- Wolff, A.C.; Hammond, M.E.H.; Hicks, D.G.; Dowsett, M.; McShane, L.M.; Allison, K.H.; Allred, D.C.; Bartlett, J.M.; Bilous, M.; Fitzgibbons, P.; et al. Recommendations for human epidermal growth factor receptor 2 testing in breast cancer: American Society of Clinical Oncology/College of American Pathologists clinical practice guideline update. J. Clin. Oncol. 2013, 31, 3997–4013. [Google Scholar] [CrossRef]
- HerceptTest™. For Determination of HER2 Protein Overexpression. In Catalog Products and Services; DAKO: Jena, Germany, 2007; pp. 86–87. [Google Scholar]
- Denkert, C.; Loibl, S.; Müller, B.M.; Eidtmann, H.; Schmitt, W.D.; Eiermann, W.; Gerber, B.; Tesch, H.; Hilfrich, J.; Huober, J.; et al. Ki67 levels as predictive and prognostic parameters in pretherapeutic breast cancer core biopsies: A translational investigation in the neoadjuvant GeparTrio trial. Ann. Oncol. 2013, 24, 2786–2793. [Google Scholar] [CrossRef]
- McGhan, L.J.; McCullough, A.E.; Protheroe, C.A.; Dueck, A.C.; Lee, J.J.; Nunez-Nateras, R.; Castle, E.P.; Gray, R.J.; Wasif, N.; Goetz, M.P.; et al. Androgen receptor-positive triple negative breast cancer: A unique breast cancer subtype. Ann. Surg. Oncol. 2014, 21, 361–367. [Google Scholar] [CrossRef]
- McNamara, K.M.; Yoda, T.; Nurani, A.M.; Shibahara, Y.; Miki, Y.; Wang, L.; Nakamura, Y.; Suzuki, K.; Yang, Y.; Abe, E.; et al. Androgenic pathways in the progression of triple-negative breast carcinoma: A comparison between aggressive and non-aggressive subtypes. Breast Cancer Res. Treat. 2014, 145, 281–293. [Google Scholar] [CrossRef]
- Ricciardelli, C.; Bianco-Miotto, T.; Jindal, S.; Butler, L.M.; Leung, S.; McNeil, C.M.; O’Toole, S.A.; Ebrahimie, E.; Millar, E.K.A.; Sakko, A.J.; et al. The magnitude of androgen receptor positivity in breast cancer is critical for reliable prediction of disease outcome. Clin. Cancer Res. 2018, 24, 2328–2341. [Google Scholar] [CrossRef]
- Kolyvas, E.A.; Caldas, C.; Kelly, K.; Ahmad, S.S. Androgen receptor function and targeted therapeutics across breast cancer subtypes. Breast Cancer Res. 2022, 24, 79. [Google Scholar] [CrossRef] [PubMed]
- Qu, Q.; Mao, Y.; Fei, X.C.; Shen, K.W. The impact of androgen receptor expression on breast cancer survival: A retrospective study and meta-analysis. PLoS ONE 2013, 8, e82650. [Google Scholar] [CrossRef] [PubMed]
- Bozovic-Spasojevic, I.; Zardavas, D.; Brohée, S.; Ameye, L.; Fumagalli, D.; Ades, F.; de Azambuja, E.; Bareche, Y.; Piccart, M.; Paesmans, M.; et al. The prognostic role of androgen receptor in patients with early-stage breast cancer: A metaanalysis of clinical and gene expression data. Clin. Cancer Res. 2017, 23, 2702–2712. [Google Scholar] [CrossRef] [PubMed]
- Sainsbury, J.R.; Farndon, J.R.; Needham, G.K.; Malcolm, A.J.; Harris, A.L. Epidermal-growth-factor receptor status as predictor of early recurrence of and death from breast cancer. Lancet 1987, 1, 1398–1402. [Google Scholar] [CrossRef]
- Salomon, D.S.; Brandt, R.; Ciardiello, F.; Normanno, N. Epidermal growth factor-related peptides and their receptors in human ma-lignancies. Crit. Rev. Oncol. Hematol. 1995, 19, 183–232. [Google Scholar] [CrossRef]
- Burness, M.L.; Grushko, T.A.; Olopade, O.I. Epidermal growth factor receptor in triplenegative and basal-like breast cancer: Promising clinical target or only a marker? Cancer J. 2010, 16, 23–32. [Google Scholar] [CrossRef]
- Zakaria, Z.; Zulkifle, M.F.; Wan Hasan, W.A.N.; Azhari, A.K.; Abdul Raub, S.H.; Eswaran, J.; Soundararajan, M.; Syed Husain, S.N.A. Epidermal growth factor receptor (EGFR) gene alteration and protein overexpression in Malaysian triple-negative breast cancer (TNBC) cohort. Onco Targets Ther. 2019, 12, 7749–7756. [Google Scholar] [CrossRef]
- Medić-Milijić, N.; Jovanić, I.; Nedeljković, M.; Marković, I.; Spurnić, I.; Milovanović, Z.; Ademović, N.; Tomić, T.; Tanić, N.; Tanić, N. Prognostic and Clinical Significance of PD-L1, EGFR and Androgen Receptor (AR) Expression in Triple-Negative Breast Cancer (TNBC) Patients. Life 2024, 14, 682. [Google Scholar] [CrossRef]
- Rakha, E.A.; El-Sayed, M.E.; Green, A.R.; Lee, A.H.; Robertson, J.F.; Ellis, I.O. Prognostic markers in triple-negative breast cancer. Cancer 2007, 109, 25–32. [Google Scholar] [CrossRef]
- Loibl, S.; Müller, B.M.; von Minckwitz, G.; Schwabe, M.; Roller, M.; Darb-Esfahani, S.; Ataseven, B.; du Bois, A.; Fissler-Eckhoff, A.; Gerber, B.; et al. Androgen receptor expression in primary breast cancer and its predictive and prognostic value in patients treated with neoadjuvant chemotherapy. Breast Cancer Res. Treat. 2011, 130, 477–487. [Google Scholar] [CrossRef]
- He, J.; Peng, R.; Yuan, Z.; Wang, S.; Peng, J.; Lin, G.; Jiang, X.; Qin, T. Prognostic value of androgen receptor expression in operable triple-negative breast cancer: A retrospective analysis based on a tissue microarray. Med. Oncol. 2012, 29, 406–410. [Google Scholar] [CrossRef] [PubMed]
- Tang, D.; Xu, S.; Zhang, Q.; Zhao, W. The expression and clinical significance of the androgen receptor and E-cadherin in triple-negative breast cancer. Med. Oncol. 2012, 29, 526–533. [Google Scholar] [CrossRef] [PubMed]
- Pistelli, M.; Caramanti, M.; Biscotti, T.; Santinelli, A.; Pagliacci, A.; De Lisa, M.; Ballatore, Z.; Ridolfi, F.; Maccaroni, E.; Bracci, R.; et al. Androgen receptor expression in early triple-negative breast cancer: Clinical significance and prognostic associations. Cancers 2014, 6, 1351–1362. [Google Scholar] [CrossRef] [PubMed]
- Noh, S.; Kim, J.Y.; Koo, J.S. Metabolic differences in estrogen receptor-negative breast cancer based on androgen receptor status. Tumour Biol. 2014, 35, 8179–8192. [Google Scholar] [CrossRef]
- Thompson, K.J.; A Leon-Ferre, R.; Sinnwell, J.P.; Zahrieh, D.M.; Suman, V.J.; Metzger, F.O.; Asad, S.; Stover, D.G.; Carey, L.; Sikov, W.M.; et al. Luminal androgen receptor breast cancer subtype and investigation of the microenvironment and neoadjuvant chemotherapy response. NAR Cancer 2022, 4, zcac018. [Google Scholar] [CrossRef]
- Safi, R.; Wardell, S.E.; Watkinson, P.; Qin, X.; Lee, M.; Park, S.; Krebs, T.; Dolan, E.L.; Blattler, A.; Tsuji, T.; et al. Androgen receptor monomers and dimers regulate opposing biological processes in prostate cancer cells. Nat. Commun. 2024, 15, 7675. [Google Scholar] [CrossRef]
- Singaravelu, I.; Spitz, H.; Mahoney, M.; Dong, Z.; Kotagiri, N. Antiandrogen Therapy Radiosensitizes Androgen Receptor-Positive Cancers to 18F-FDG. J. Nucl. Med. 2022, 63, 1177–1183. [Google Scholar] [CrossRef]
- Christenson, J.L.; O’Neill, K.I.; Williams, M.M.; Spoelstra, N.S.; Jones, K.L.; Trahan, G.D.; Reese, J.; Van Patten, E.T.; Elias, A.; Eisner, J.R.; et al. Activity of Combined Androgen Receptor Antagonism and Cell Cycle Inhibition in Androgen Receptor Positive Triple Negative Breast Cancer. Mol. Cancer Ther. 2021, 20, 1062–1071. [Google Scholar] [CrossRef]
- Lim, B.; Seth, S.; Yam, C.; Huo, L.; Fujii, T.; Lee, J.; Bassett, R.; Nasser, S.; Ravenberg, L.; White, J.; et al. Phase 2 study of neoadjuvant enzalutamide and paclitaxel for luminal androgen receptor-enriched TNBC: Trial results and insights into “ARness”. Cell Rep. Med. 2024, 5, 101595. [Google Scholar] [CrossRef]
- Popovic, L.S.; Matovina-Brko, G.; Popovic, M.; Punie, K.; Cvetanovic, A.; Lambertini, M. Targeting triple-negative breast cancer: A clinical perspective. Oncol. Res. 2023, 31, 221–238. [Google Scholar] [CrossRef]

| Charasteristics | Median (Range) |
|---|---|
| Age (years) | 58.5 (30–88) |
| Tumor size (cm) * | n (%) |
| ≤2 | 37 (29.8) |
| 2–5 | 75 (60.5) |
| >5 | 11 (8.9) |
| Unknown | 1 (0.8) |
| N (number of LNM) ** | n (%) |
| 0 | 78 (62.9) |
| 1–3 | 36 (29.0) |
| 4+ | 9 (7.3) |
| Unknown | 1 (0.8) |
| Tumor grade | n (%) |
| II | 58 (48.6) |
| III | 66 (53.2) |
| Ki-67 % score | n (%) |
| ≤14 | 12 (9.7) |
| 15–30 | 14 (11.3) |
| ≥30 | 98 (79.0) |
| Androgen receptor (AR) | n (%) |
| negative (≤10%) | 81 (65.3) |
| positive (>10%) | 43 (34.7) |
| Cytokeratin (CK) 5/6 score | n (%) |
| negative (<4) | 77 (62.1) |
| positive (≥4) | 47 (37.9) |
| EGFR score | n (%) |
| negative (<4) | 82 (66.1) |
| positive (≥4) | 42 (33.9) |
| Tumor type | n (%) |
| non-basal | 57 (46.0) |
| basal-like | 67 (54.0) |
| Type of surgery | n (%) |
| breast-conserving surgery | 54 (43.5) |
| mastectomy | 70 (56.5) |
| Adjuvant chemotherapy | n (%) |
| no | 33 (26.6) |
| yes | 91 (73.4) |
| Adjuvant radiotherapy | n (%) |
| no | 43 (34.7) |
| yes | 81 (65.3) |
| Disease relapse | n (%) |
| no | 87 (70.2) |
| yes | 37 (29.8) |
| Patients’ outcome | n (%) |
| Alive | 76 (61.3) |
| Died | 48 (38.7) |
| Total | 124 (100%) |
| 5-year FUP | Mean value (95%CI) |
| DFS (months) | 44.3 (40.5–48.2) |
| OS (months) | 48.3 (44.9–51.7) |
| Charasteristics | AR-Negative | AR-Positive | p-Value |
|---|---|---|---|
| (n = 81) | (n = 43) | ||
| Age (years; mean ± SD) | 57.7 ± 11.9 | 59.9 ± 11.3 | 0.318 |
| Tumor size (cm) | n (%) | n (%) | 0.051 |
| ≤2 | 21 (25.9) | 16 (37.2) | |
| 2–5 | 53 (65.4) | 22 (51.2) | |
| >5 | 7 (8.6) | 4 (9.3) | |
| Unknown | 0 | 1 (2.3) | |
| N status (number of LNM) | N (%) | N (%) | 0.858 |
| 0 | 51 (63.0) | 27 (62.8) | |
| 1–3 | 23 (28.4) | 13 (30.2) | |
| 4+ | 6 (7.4) | 3 (7.0) | |
| Unknown | 1 (1.2) | 0 | |
| Tumor grade | n (%) | n (%) | 0.065 |
| II | 33 (40.7) | 25 (58.1) | |
| III | 48 (59.3) | 18 (41.9) | |
| Ki-67 % score | n (%) | n (%) | <0.001 * |
| ≤14 | 1 (1.2) | 11 (25.6) | |
| 15–30 | 6 (7.4) | 8 (18.6) | |
| >30 | 74 (91.4) | 24 (55.8) | |
| Cytokeratin (CK) 5/6 score | n (%) | n (%) | 0.371 |
| negative (<4) | 48 (59.3) | 29 (67.4) | |
| positive (≥4) | 33 (40.7) | 14 (32.6) | |
| EGFR score | n (%) | n (%) | 0.822 |
| negative (<4) | 53 (65.4) | 29 (67.4) | |
| positive (≥4) | 28 (34.6) | 14 (32.6) | |
| Type of surgery | n (%) | n (%) | 0.917 |
| Breast-conserving surgery | 35 (43.2) | 19 (44.2) | |
| Mastectomy | 46 (56.8) | 24 (55.8) | |
| Adjuvant Chemotherapy | n (%) | n (%) | 0.850 |
| No | 22 (22.7) | 11 (25.6) | |
| Yes | 59 (72.8) | 32 (74.4) | |
| Adjuvant radiotherapy | n (%) | n (%) | 0.972 |
| No | 28 (34.6) | 15 (34.9) | |
| Yes | 53 (65.4) | 28 (65.1) |
| Charasteristics | 5-Year DFS | 5-Year OS | ||
|---|---|---|---|---|
| HR (95% CI) | p Value | HR (95% CI) | p Value | |
| Age | 1.04 (1.01–1.06) | 0.010 * | 1.04 (1.01–1.07) | 0.007 * |
| Tumor size | 3.18 (1.83–5.53) | <0.001 * | 4.31 (2.37–7.85) | <0.001 * |
| Nodal status | 2.23 (1.5–3.32) | <0.001 * | 1.76 (1.13–2.73) | 0.012 * |
| Tumor grade | 0.61 (0.34–1.09) | 0.092 | 0.64 (0.34–1.2) | 0.165 |
| Ki-67% score | 0.76 (0.51–1.13) | 0.171 | 0.95 (0.58–1.53) | 0.822 |
| AR (>10% vs. ≤10%) | 0.57 (0.3–1.09) | 0.089 | 0.55 (0.27–1.12) | 0.099 |
| CK 5/6 score (≥4 vs. <4) | 1.33 (0.75–2.36) | 0.333 | 2.07 (1.1–3.89) | 0.024 * |
| EGFR score (≥4 vs. <4) | 1.99 (1.12–3.54) | 0.019 * | 2.4 (1.28–4.5) | 0.007 * |
| Type of surgery (yes vs. no) | 0.82 (0.46–1.47) | 0.501 | 0.62 (0.32–1.2) | 0.154 |
| Adjuvant chemotherapy (yes vs. no) | 0.41 (0.23–0.74) | 0.003 * | 0.32 (0.17–0.6) | <0.001 * |
| Adjuvant radiotherapy (yes vs. no) | 0.6 (0.33–1.06) | 0.079 | 0.42 (0.22–0.78) | 0.006 * |
Disclaimer/Publisher’s Note: The statements, opinions and data contained in all publications are solely those of the individual author(s) and contributor(s) and not of MDPI and/or the editor(s). MDPI and/or the editor(s) disclaim responsibility for any injury to people or property resulting from any ideas, methods, instructions or products referred to in the content. |
© 2025 by the authors. Licensee MDPI, Basel, Switzerland. This article is an open access article distributed under the terms and conditions of the Creative Commons Attribution (CC BY) license (https://creativecommons.org/licenses/by/4.0/).
Share and Cite
Spurnić, I.; Šušnjar, S.; Jovanić, I.; Medić-Miljić, N.; Milovanović, Z.; Popović Krneta, M.; Bukumirić, Z.; Gavrilović, D.; Rajšić, S.; Marković, I. The Diagnostics of Disease Relapse Within Five-Year Follow-Up and the Role of Androgen Receptor Expression in Patients with Early Triple-Negative Breast Cancer. Diagnostics 2025, 15, 692. https://doi.org/10.3390/diagnostics15060692
Spurnić I, Šušnjar S, Jovanić I, Medić-Miljić N, Milovanović Z, Popović Krneta M, Bukumirić Z, Gavrilović D, Rajšić S, Marković I. The Diagnostics of Disease Relapse Within Five-Year Follow-Up and the Role of Androgen Receptor Expression in Patients with Early Triple-Negative Breast Cancer. Diagnostics. 2025; 15(6):692. https://doi.org/10.3390/diagnostics15060692
Chicago/Turabian StyleSpurnić, Igor, Snežana Šušnjar, Irena Jovanić, Nataša Medić-Miljić, Zorka Milovanović, Marina Popović Krneta, Zoran Bukumirić, Dušica Gavrilović, Saša Rajšić, and Ivan Marković. 2025. "The Diagnostics of Disease Relapse Within Five-Year Follow-Up and the Role of Androgen Receptor Expression in Patients with Early Triple-Negative Breast Cancer" Diagnostics 15, no. 6: 692. https://doi.org/10.3390/diagnostics15060692
APA StyleSpurnić, I., Šušnjar, S., Jovanić, I., Medić-Miljić, N., Milovanović, Z., Popović Krneta, M., Bukumirić, Z., Gavrilović, D., Rajšić, S., & Marković, I. (2025). The Diagnostics of Disease Relapse Within Five-Year Follow-Up and the Role of Androgen Receptor Expression in Patients with Early Triple-Negative Breast Cancer. Diagnostics, 15(6), 692. https://doi.org/10.3390/diagnostics15060692

